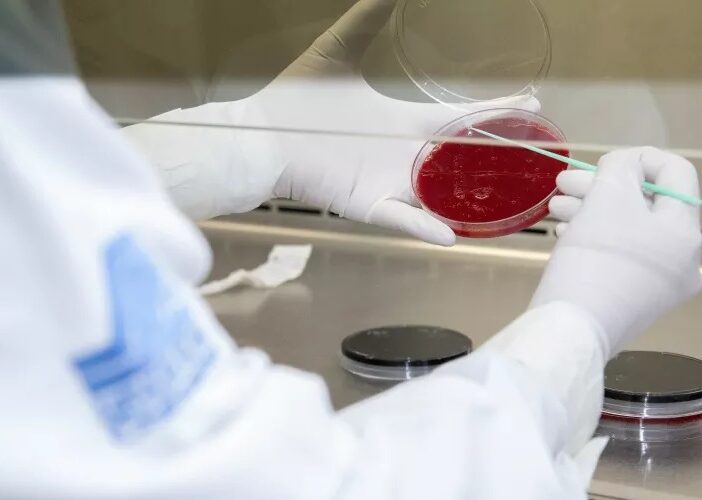

De acuerdo con información compartida por el Departamento de Salud Pública de El Paso, Texas, autoridades sanitarias estadounidenses confirmaron la existencia del primer caso de “viruela del mono” en su ciudad.
Indicó que se trata de una persona de 50 años de edad, que fue detectada con síntomas como erupción en la piel, por lo que recibió atención médica y se le ordenó permanecer bajo cuarentena al interior de su domicilio.
Por el momento, las autoridades trabajan en el rastreo de familiares y personas que pudieron tener un contacto cercano con el paciente, para prevenir que la enfermedad se propague.

De acuerdo con información de personal de la Secretaría de Salud del estado, en lo que va de 2025 Chihuahua ha registrado seis casos a lo largo de 2025. En Ciudad Juárez se dio una persona con resultado positivo a ese contagio.
Mencionó que el último caso del que se tiene registro es de inicios de diciembre, cuando autoridades sanitarias confirmaron un caso positivo en la capital del estado, lugar que llegó a los cuatro contagios confirmados.
Esta es una enfermedad altamente contagiosa que se da cuando el paciente tiene contacto directo (piel a piel) con otra persona. Entre los síntomas se incluye la erupción cutánea, dolor de cabeza, fiebre, dolor muscular, entre otros.
Las principales personas que pueden sufrir complicaciones son los pacientes de VIH, de Infecciones de Transmisión Sexual (ITS), cáncer, mujeres embarazadas y niños, por lo que se recomienda poner especial atención al momento de que se presenten síntomas parecidos a la varicela.
De igual manera, se indicó que es una enfermedad para la que no existe un tratamiento específico, por lo que se trabaja en evitar un brote de contagio.

Confirman dos casos de viruela del mono en El Paso, Texas
Son dos hombres de cerca de 40 años que viven juntos
Por Redacción

Revisa México el uso de vacuna contra la viruela del mono
Se trata del biológico que distribuye la empresa danesa Bavarian Nordic
Por Redacción

Se han reportado 53 casos de viruela símica a nivel nacional
Los dos casos sospechosos que había en Chihuahua fueron descartados por la Secretaría de Salud estatal
Por Redacción

Descartan uno de los dos supuestos casos de viruela del mono en Juárez
Se informó que los pacientes permanecerán en aislamiento hasta su recuperación
Por Redacción